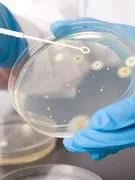

Dents : ce qu’elles révèlent de votre santé !

Gencives qui saignent : une carence en vitamine C ?

Quand les gencives saignent fréquemment au brossage, sont enflammées, il s'agit souvent d'une gingivite. Il ne faut pas la prendre à la légère.
Pourquoi ? « La gingivite est un signe précurseur du déchaussement dentaire » prévient le Dr Couzinou. A quoi est-elle due ? « Elle peut être d’origine bactérienne, provoquée par un mauvais brossage ou un brossage absent, une déficience en vitamines (C, B…), du stress… », indique par exemple le Dr Francis Mora, dentiste.
Que faire ? Le brossage des dents doit se faire après chaque repas, et avec une brosse à dents pas trop dure. Il est important de consulter rapidement un dentiste si vos gencives sont enflammées.
Déchaussement de dents : gare aux microbes !

Le déchaussement des dents est une maladie inflammatoire d'origine infectieuse. Cela peut démarrer à l'âge adulte. Il faut être vigilant sur l'hygiène dentaire.
Pourquoi ? « Le déchaussement est dû à des dépôts sur la gencive qui entraînent une inflammation. L’os qui tient la dent se rétracte », explique le Dr Christian Couzinou. Derrière les dépôts se cachent des microbes, parfaitement bien identifiés, présents dans la plaque dentaire et la salive.
Que faire ? Le spécialiste recommande de se laver les dents après chaque repas, à l’intérieur et à l’extérieur des dents. Evitez aussi l’usage de brosses à dents trop dures qui agressent les gencives.
Dents grises : surveillez vos médicaments !

Avoir les dents grises n’a rien à avoir avec l’accumulation de dépôts sur l’émail des dents, comme c’est le cas quand elles sont jaunes.
Pourquoi ? « La prise de médicaments comme les tétracyclines pendant la grossesse peut rendre les dents grises. Il peut aussi s’agir de dents non traitées ou dépulpées » prévient le Dr Francis Mora, dentiste. Une teinte grise sur les dents peut aussi être naturelle. « Quand on vieillit, l’émail s’use et est moins épais, les dents deviennent alors grises », ajoute le Dr Christian Couzinou, président du Conseil national de l’ordre des chirurgiens-dentistes.
Que faire ? Il est conseillé ici de ne pas utiliser de brosses à dents à poils durs. Sur l’emballage, privilégiez celle ayant un poil au 20/100e. N'arrêtez jamais un traitement médicamenteux sans avoir consulté votre médecin.
Perte des dents : gare à l’ostéoporose !

L’ostéoporose est une maladie qui affecte tous les os du corps, y compris ceux de la mâchoire. La conséquence : le déchaussement puis la perte des dents.
Pourquoi ? L’ostéoporose est associée à une diminution de la masse osseuse. En janvier 2007, le Pr Keith Horner et le Dr Hugh Devlin de l'université de Manchester se sont rendus compte qu’en mesurant l’épaisseur d’une partie de la mâchoire inférieure via l’utilisation de rayons X, il était possible de mieux dépister le risque d’ostéoporose (1).
Que faire ? Faire surveiller sa dentition une à deux fois par an et adopter une bonne hygiène buccale.
A noter : Les biphosphonates prescrits pour le traitement ou la prévention de fractures osseuses lors d’ostéoporose ont été associés à des cas d’ostéonécroses (mort des os de la mâchoire). Prévenez votre dentiste si vous en prenez.
(1) Bone, janvier 2007
Dents jaunes : méfiez-vous des dentifrices

Le jaunissement dentaire caractérise la formation de dépôts sur la surface des dents.
Pourquoi ? « Plusieurs causes sont possibles : du tartre, le tabac, l’utilisation d’ antiseptiques locaux à base de chlorhexidine comme des bains de bouche, des sprays et des dentifrices », indique le Dr Francis Mora, dentiste. Le consommation régulière de thé et de café peut également jaunir les dents.
Que faire ? Limiter l’usage de produits à base de chlorhexidine (regardez sur les étiquettes, sa présence y est indiquée), ainsi que la consommation de thé et de café. Quant au tabac, pour toutes les raisons que l’on connaît, il est fortement recommandé d’arrêter de le fumer.
Gencives blanches : un signe d'anémie

Des gencives blanches peuvent être le signe d’une anémie.
Pourquoi ? C'est l'hémoglobine qui donne la couleur rouge au sang et la couleur rosée au niveau de la peau et des muqueuses. Or, en cas d'anémie, il y a une importante diminution du taux d’hémoglobine dans le sang, d’où la pâleur.
Que faire ? Si vous constatez que vos gencives sont blanches, et plus généralement vos lèvres, votre visage, que vous êtes fatigué même lorsque vous ne faites aucun effort, et ce de façon persistante, consultez votre médecin.
Stries sur les dents : changez de brosse à dents !

Nous sommes nombreux à remarquer des stries sur nos dents.
Pourquoi ? « Il peut s’agir d’un défaut de la dent, mais le plus souvent le responsable est la brosse à dents trop dure », explique le Dr Christian Couzinou, chirurgien-dentiste.
Que faire ? Changez de brosse à dents pour une plus souple. Dans tous les cas, se laver les dents après chaque repas et consulter un dentiste une à deux fois par an.
Parodontite : des bactéries à risque pour votre coeur
La parodontite toucherait 10 à 20% de la population. Causée par la présence de bactéries, elle aboutie à la destruction de l’os qui soutient la dent. Elle ne doit pas être négligée car elle peut avoir de graves complications.
Pourquoi ? « On s’est aperçu que dans les caillots responsables d’infarctus ou d’accidents vasculaires cérébraux, on retrouvait des microbes provenant des parodontes », prévient le Dr Couzinou. De plus, une parodontite peut déséquilibrer un diabète et inversement, être le signe d’un diabète déséquilibré (trop de sucres dans le sang fragilise le parodonte).
Que faire ? Une parodontite est souvent indolore. Il est ainsi essentiel de consulter un dentiste une à deux fois par an pour surveiller. Avoir une bonne hygiène buccale (brossage des dents après chaque repas…) et de vie (pas de tabac, moins de stress) participe à la prévention de cette maladie.
Email des dents usé : un trouble alimentaire ?

Les désordres alimentaires comme la boulimie et l’anorexie peuvent abîmer les dents. Notamment, user l’émail.
Pourquoi ? L’acidité des vomissements répétés use l’émail des dents qui peut disparaître totalement, les dents prenant alors une couleur jaune et présentant une sensibilité accrue au froid et au chaud.
Que faire ? Déjà, éviter le brossage des dents après les vomissements qui ne font qu’aggraver les dégâts sur l’émail. Et plutôt rincer la bouche avec de l’eau. Ensuite, en parler au médecin traitant ou aux autres professionnels de santé (dentistes, psychologues…).